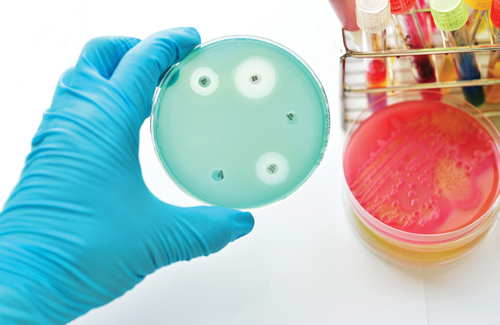

Welcome To ZOTA Pharmaceutical
Zota pharmaceuticals are an emergent, swiftly developing a Pharmaceutical company with proven capabilities in the area of product innovation, product research, manufacturing, and marketing. Our goal is to ensure that patients shall have the right to use high quality and affordable medicines. Zota pharma is working in the arms of manufactures called Atoz pharmaceuticals Pvt Ltd which is responsible to take care of the domestic market. Our products would maintain a reputation for high quality and best possible performance. We have been privileged and fortunate to be the exporter of more than 10 leading countries for the betterment of peoples. Soon will be known for our innovative products and leading-edge science to advance patient care. Our products would continue the reputation for special quality and best potential enforcement. Right from the acquirement till complete formulations, our stringent modes assure that the products are safe, effective and compliant with the Universal standards.
We Treat
For primary general diseases in all leading countries with major practitioners
who repeatedly prescribing our products with confidence.